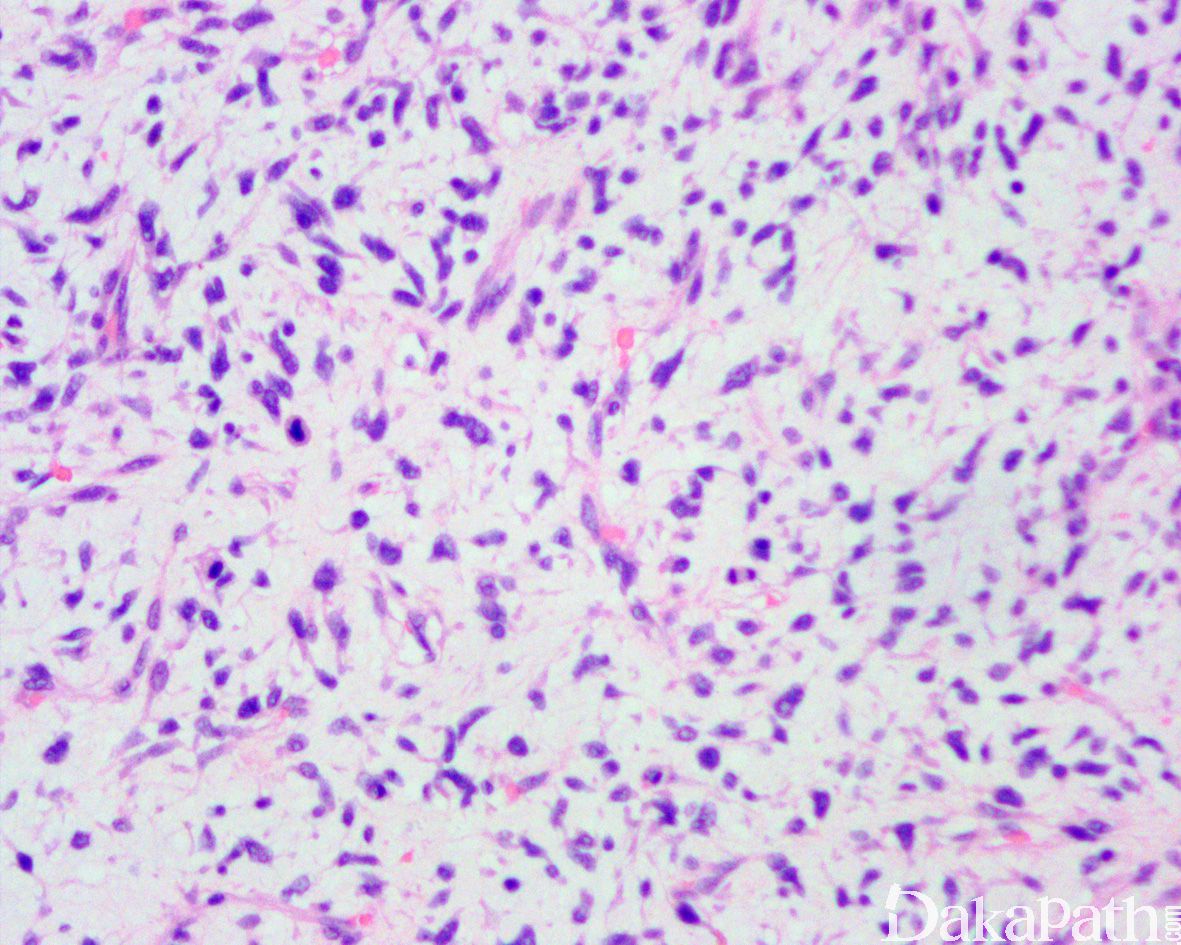
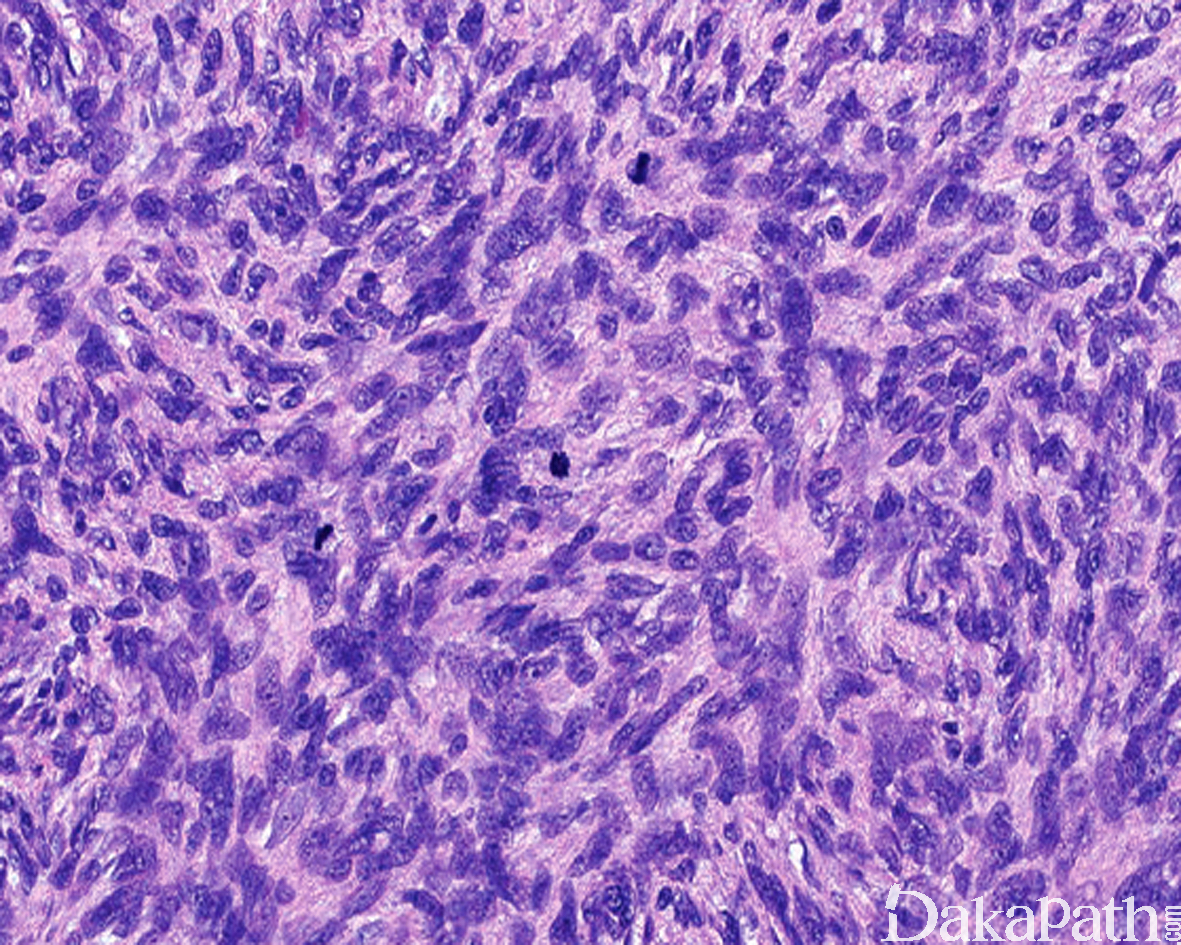

隆突性皮肤纤维肉瘤
Dermatofibrosarcoma Protuberans,DFSP
概述:
一种发生于皮肤的低度恶性纤维母细胞性肿瘤,组织学上由单型性的梭形细胞呈致密的席纹状结构组成,伴蜂窝状浸润皮下脂肪组织。
发病部位: 肿瘤好发于躯干(包括胸壁、腹壁和背部)、四肢近端和头颈部(特别是头皮),偶可发生于外阴和腮腺等少见部位,但极少发生于四肢远端。
诊断要点:
多发生于中青年,偶然见于婴幼儿和老年人;
好发于躯干、四肢近端和头颈部,偶见于肢体远端;
大体上早期病变表现为真皮隆起的斑块,随着疾病的发展,肿瘤表现为隆起于皮肤表面的单个或多个结节性肿块,有时可见溃疡形成;切面灰白灰褐色,可见黏液变性、出血或色素沉积,罕见坏死,边界通常不清,有时大体上可表现为界限清楚,但镜下观察通常可见浸润性边界;
肿瘤主要位于真皮层,弥漫浸润性生长,浸润脂肪组织形成特征性的蜂窝状或蕾丝样 (或称花边样)浸润图像;
瘤细胞均匀较一致,呈两端细长的纤维母细胞样,呈一致的致密的席纹状排列,少数病例内可见局灶的血管外皮瘤样排列;
瘤细胞常紧密围绕残留的汗管等皮肤附件组织;
瘤细胞核异型性并不明显,核分裂像通常较低(0 ~ 10/10HPF);
间质偶见淋巴细胞、多核巨细胞、黄瘤样细胞聚集,罕见出血、含铁血黄素沉积和肿瘤性坏死;
表皮常呈萎缩性改变,不同于纤维组织细胞瘤中常见的表皮棘皮瘤样增生性改变;
部分病例可见局灶的间质黏液变性,黏液区瘤细胞缺乏席纹状结构,瘤细胞呈星芒状,间质微血管网增生明显;
约 1-5%的 DFSP 可见散在或成片分布的富于黑色素的梭形、树突状肌上皮样细胞,称为 Bednar 瘤;
部分病例可见瘤细胞的区域性分布表现为富于细胞区过渡为具有丰富的玻璃样胶原性间质的低密度区,当胶原基质较多时瘤细胞可呈类似于神经鞘瘤可见的栅栏状核排列;
部分病例可见局灶的肌样结节形成,表现为明显嗜酸性的肌性结节,其内可见偏心性的血管样腔隙,提示肌性结节可能是异常发育的血管壁的斜切面所致;
约 10%的 DFSP 可见高级别转化,表现为瘤细胞密度高,呈长束状或鱼骨样排列,组织学上类似于成人型纤维肉瘤,又称为 DFSP 伴有纤维肉瘤样转化,纤维肉瘤样转化灶通常位于皮下,瘤细胞可见较大的异型性和明显增高的核分裂象,约 1%可见 DFSP 转化为明显的多形性瘤细胞特征,类似于多形性未分化肉瘤;

免疫组织化学染色:
DFSP 通常表达 CD34,不表达 S100 蛋白,EMA, CK, FXIIIa, desmin 和 CD117, 部分可局灶表达 SMA;伴有纤维肉瘤样转化的 DFSP 转化区 CD34 表达减少,过表达 P53;富于黑色素的梭形或树突状细胞表达 HMB45. Melan-A 和 S100 蛋白。
分子标记:
染色体 17 和 22 的超额环状染色体或 t(17;22)转位,均可导致 COLIA1-PDGFβ 基因融合
鉴别诊断:
纤维组织细胞瘤:表皮常呈棘皮瘤样增生,取代而不是内陷周围的皮肤附属器结构,常伴有多核巨细胞、黄瘤样组织细胞以及含铁血黄素的混合,除了席纹状结构之外,另可见不规则束状或随意的分布结构,多不表达 CD34;
弥漫性和色素性神经纤维瘤:除了表达 CD34 之外,尚表达 S100 蛋白和 SOX10;
浅表性恶性外周神经鞘膜瘤:通常起源于神经干,无单调一致的席纹状结构,可见血管内生长、地图状坏死,瘤细胞局灶表达 S100 蛋白和 SOX10,特征性的显示 H3K27me3 表达缺失;
黏液纤维肉瘤:黏液变异型 DFSP 需要与黏液纤维肉瘤区别;黏液纤维肉瘤瘤细胞的异型性更明显,常见血管周围聚集和假脂肪母细胞
黏液脂肪肉瘤:粘液变异型 DFSP 亦需要与黏液性脂肪肉瘤区别;黏液脂肪肉瘤多位于皮下或肌内,罕见累及真皮,病变内可见复杂的鸡爪样血管网,瘤细胞呈卵圆形,可见单泡或多泡状脂肪母细胞,免疫组化染色表达 S100 蛋白;
成人型纤维肉瘤:非常罕见,从前诊断的成年型纤维肉瘤现在多为其他类似的软组织肉瘤,其中较多为纤维肉瘤样转化的 DFSP,广泛取材寻找典型的 DFSP 灶可资鉴别;
成脂肪的孤立性纤维性肿瘤:皮下发生为主,病变多界限清楚,脂肪组织为肿瘤的一部分而非浸润而累及的脂肪, 以血管外皮瘤样结构为主,仅见局灶的席纹状结构,免疫组化染色除了表达 CD34 之外,尚特征性的表达 STAT6 可资鉴别。
治疗:
主要采用局部广泛切除术,并确保切缘没有肿瘤残留,需要长期随访。
参考文献:
Thway K , Noujaim J , Jones R L , et al. Dermatofibrosarcoma protuberans: pathology, genetics, and potential therapeutic strategies[J]. Annals of Diagnostic Pathology, 2016, 25:64-71. Walluks K , Chen Y , Woelfel C , et al. Molecular and clinicopathological analysis of dermatofibrosarcoma protuberans[J]. Pathology - Research and Practice, 2013, 209(1):30-35. Reimann J D R , Fletcher C D M . Myxoid Dermatofibrosarcoma Protuberans: A Rare Variant Analyzed in a Series of 23 Cases[J]. The American Journal of Surgical Pathology, 2007, 31(9):1371-1377. Ha SY, Lee SE, Kwon MJ, et al. PDGFB rearrangement in dermatofibrosarcoma protuberans: correlation with clinicopathologic characteristics and clinical implications. Hum Pathol. 2013;44: 1300–1309.
